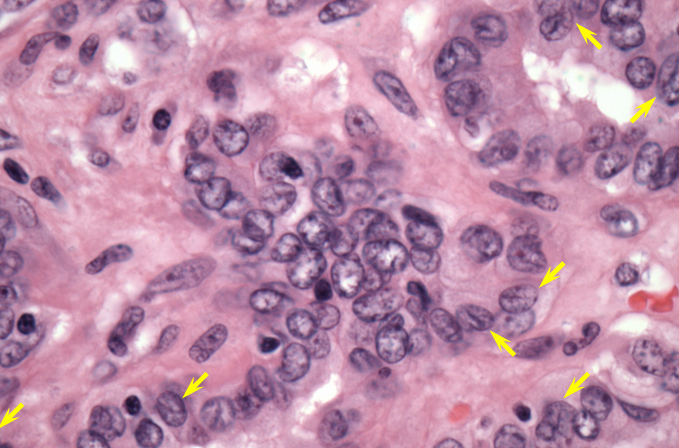
term image
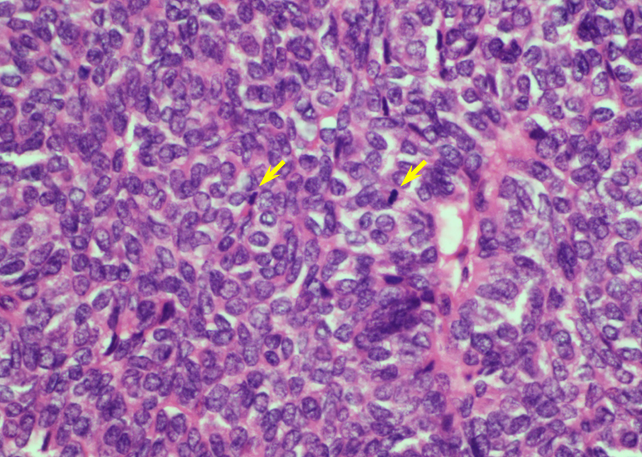
term image
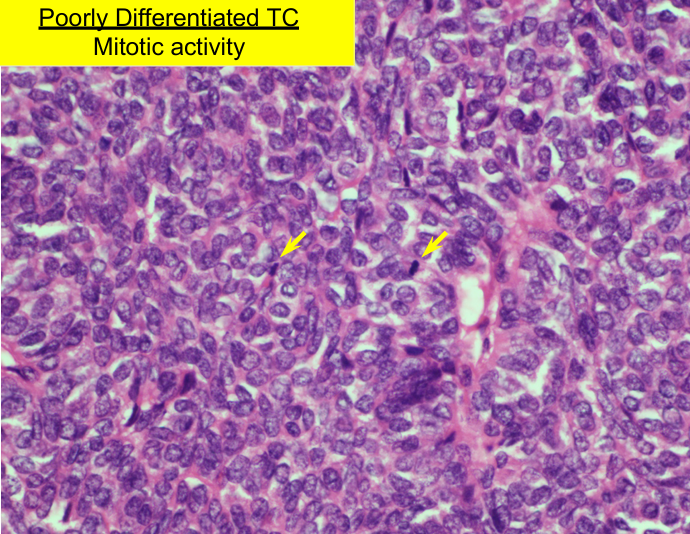
knowt flashcard image

1/337
Looks like no tags are added yet.
Name | Mastery | Learn | Test | Matching | Spaced |
|---|
No study sessions yet.
thyroid anatomy

thyroid structure

thyroid structure- follicles

iodine

how much iodine do you need?

IOM: RDA for iodine, foods with iodine

iodine deficiency

iodine content in pharmaceuticals

iodine metabolism

why give KI in nuclear accidents/fallout?

hypothalamic-pituitary-thyroid axis

overview of thyroid hormone synthesis

thyroid hormone synthesis

detailed thyroid hormone synthesis

1) iodide trapping

2) iodide transport

2b) making TG (thyroglobulin)

3) oxidation + organification → T4 + T3

organification + coupling →
-thyroid hormone

4-7) proteolysis + release

thyroid hormone circulation

cellular action of thyroid hormones- T3

TH intracellular action

thyroid hormone action

thyroid hormone action- heart, liver, adipose tissue

thyroid hormone action- gut, brain, bone, muscle, skin

serum half-life of thyroid hormones

thyroid hormone metabolism


deiodinases- D1, D2, D3

reduced peripheral conversion of T4

summary- synthesis and peripheral metabolism of thyroid hormones

hypothalamic-pituitary-thyroid axis

TSH- homologous to
-FSH, LH, HCG

log-linear relationship between plasma TSH and
-free T4

thyroid screening

thyroid function tests (TFTs)

TFTs- serum TSH, T4, T3

TFTs- ask before

high T4 levels- cause, total T4, free T4

low T4 levels- cause, total T4, free T4

points about free hormones

total T4 x T3RU =
-FTI

screening- TSH + Free T4


TSH, free T4, free T3, disease

hyperthyroidism- causes

thyrotoxicosis
-typically presents in younger patients
thyrotoxicosis- atypical presentations

diagnosis- U/S features

diagnosis- I-123 uptake and scan


-I-123 uptake and scan for thyroiditis
lab clues

Graves’ disease

Graves’ disease components/manifestations


-thyroid dermopathy (5%)
-aka pretibial myxedema
thyroid eye disease

TED manifestations and Rx

epidemiology of TED

treatment of hyperthyroidism- goals

antithyroid drugs (ATDs)

ATDs MOA- intrathyroidal

ATDs MOA- extrathyroidal

uses of ATDs in hyperthyroidism

thioureas- pharmacokinetics

using methimazole and PTU- Graves’ disease

using PTU and methimazole- preop or pre-RAI

side effects of thioureas

treatment of hyperthyroidism- inhibiting secretion of thyroid hormone

symptom relief of hyperthyroidism

beta-blockers

cure of hyperthyroidism- definitive therapy

treatment of hyperthyroidism- radioactive iodine (RAI) I-131 concerns

surgery for Graves’ disease

TSH-R antibody (TRAb/TSI) with Graves’ treatment

causes of hypothyroidism

available thyroid hormone preparations

LT4 dosing

monitoring thyroid treatment

changes in LT4 dose requirement

lab caveat- biotin

diet? supplements?

iodine in excess


-normal thyroid- lobular architecture

-normal thyroid- cuboidal follicular epithelial cells

-C cells

-C cells (hyperplastic)- calcitonin stain

-nodular hyperplasia
-disruption of follicular architecture

-papillary thyroid carcinoma- papillary architecture
papillary thyroid carcinoma- diagnosis

-PTC- nuclear grooves

-PTC- pseudoinclusions
papillary thyroid carcinoma- clinical features


follicular adenomatoid hyperplasia, follicular adenoma, MIFTC, angioinvasive FTC


-follicular adenomatoid hyperplasia
-not a distinct/discreet lesion